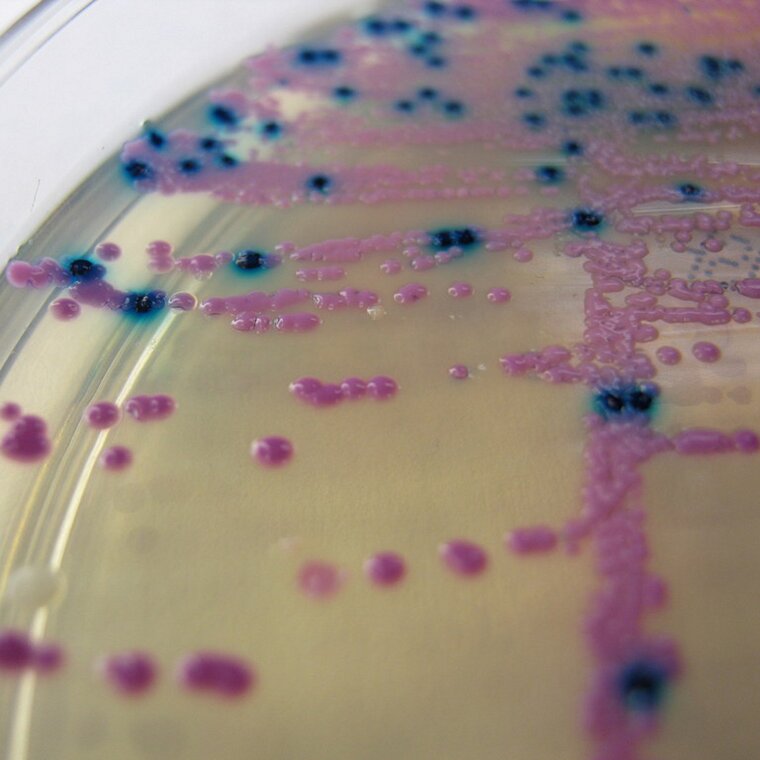

Przeczytaj
E‑materiały powiązane z tematem
Choroby bakteryjne
Choroby bakteryjne wywoływane są przez bakterie będące patogenami. Do rozwoju tych schorzeń dochodzi w wyniku wniknięcia drobnoustrojów do organizmu gospodarza, a następnie ich namnożenia. Przyczyną zakażenia mogą być również bakterie żyjące wewnątrz organizmu, tzw. mikroflora fizjologiczna, powodująca infekcje w przypadku obniżonej odporności (np. u pacjentów z AIDS) oraz np. w trakcie antybiotykoterapii.

Do chorób bakteryjnych należą m.in.: angina, zapalenie płuc, rzeżączka, gruźlica, czerwonka bakteryjna, dur brzuszny, cholera, wąglik, borelioza, tężec, dżuma, krztusiec, salmonelloza. Bakterie chorobotwórcze są też przyczyną stanów zapalnych – mogą powodować np. zapalenie zatok przynosowych czy zapalenie opon mózgowo‐rdzeniowych. W niektórych przypadkach zakażenie bakteryjne może rozwinąć się w zagrażającą życiu sepsęsepsę.
Wybrane choroby bakteryjne człowieka
Nazwa bakterii | Nazwa choroby | Droga zakażenia | Objawy |
|---|---|---|---|
Borrelia burgdorferi (krętek) | borelioza | ukąszenie przez kleszcza - nosiciela krętka |
|
Vibrio cholerae (przecinkowiec cholery) | cholera | droga pokarmowa, kontakt z chorym |
|
Shigella (pałeczka czerwonki) | czerwonka bakteryjna (dyzenteria) | droga pokarmowa |
|
Salmonella typhi | dur brzuszny | droga pokarmowa, kontakt z chorym, możliwe roznoszenie przez owady (szczególnie muchy) |
|
Mycobacterium tuberculosis (prątek gruźlicy) | gruźlica | droga kropelkowa, rzadziej droga pokarmowa |
|
Clostridium tetani | tężec | kontakt zranionej skóry z glebą, w której znajdują się laseczki tężca |
|
Bacillus anthracis (laseczka wąglika) | wąglik | droga pokarmowa, droga oddechowa, kontakt zranionej skóry z glebą, w której znajdują się laseczki wąglika, kontakt ze zwierzętami zakażonymi laseczką | objawy zależne od postaci: a) postać skórna:
b) postać jelitowa:
c) postać płucna:
|
Treponema pallidum | kiła | stosunek seksualny |
|
Neisseria gonorrhoeae (dwoinka rzeżączki) | rzeżączka | stosunek seksualny |
|
Chlamydia trachomatis (bakteria atypowa) | chlamydioza | stosunek seksualny |
|
Jak przygotować preparat mikroskopowy bakterii do barwienia Grama?
Włóż rękawiczki jednorazowe.
Wykonaj utrwalony preparat. Odtłuść szkiełko podstawowe mydłem, a następnie oczyść bibułą.
Podpisz preparat markerem, oznaczając go jako np. „Sa” (Staphylococcus aureus).
Na środek szkiełka pipetą nanieś kroplę soli fizjologicznej.
Wyżarz ezę (pętlę bakteriologiczną), trzymając ją pionowo przez kilka sekund w płomieniu palnika. Poczekaj do jej ostygnięcia.
Za pomocą ezy przenieś jedną kolonię bakterii z szalki Staphylococcus aureus i delikatnie rozmaż ją w kropli.
Suchy preparat chwyć pęsetą. Utrwal go w płomieniu palnika, przez trzykrotne przesunięcie szkiełka nad płomieniem. Odłóż preparat i czekaj, aż ostygnie.
W taki sam sposób przygotuj preparat z szalki Escherichia coli. (Powtórz punkty od 2 do 7).
Wykonaj barwienie. Przygotuj wanienkę do barwienia w zlewie. Na jej metalowych rurkach umieść szkiełka podstawowe z utrwalonymi preparatami.
Preparaty zalej fioletem krystalicznymfioletem krystalicznym, odczekaj 60 sekund.
Na preparaty nanieś płyn Lugolapłyn Lugola, odczekaj 30 sekund.
Opłucz preparaty wodą destylowaną za pomocą tryskawki.
Preparaty odbarw etanolem skażonym. Poczekaj ok. 10 sekund.
Opłucz preparaty wodą destylowaną za pomocą tryskawki.
Na preparaty nanieś fuksynę zasadowąfuksynę zasadową, odczekaj 30 sekund.
Opłucz preparaty wodą destylowaną za pomocą tryskawki.
Osusz preparaty bibułą. Pozbawione wilgoci oglądaj pojedynczo w mikroskopie świetlnym, z obiektywem immersyjnym, w powiększeniu 100×.
Obejrzyj materiał, jak prawidłowo przygotować preparat do barwienia Grama.
Zapoznaj się z opisem, jak prawidłowo przygotować preparat do barwienia Grama.
Zdjęcie przedstawia blat, na którym znajdują się cztery niewielkie butelki. Do jednej z nich jest włożona pipeta. Obok butelek znajduje się niewielka menzurka z niewielką ilością ciemnego płynu oraz niewielka butelka z dyfuzorem. Są także położone na kolorowej kartce dwa szkiełka. Szkiełko po lewej stronie, wybarwione na fioletoworóżowo z napisem Sa. Szkiełko po prawej stronie wybarwione jest na różowo z napisem Ec.
1. Instrukcja: Na środek szkiełka opisanego jako „Sa” (Staphylococcus aureus) nanieś pipetą kroplę soli fizjologicznej. Ukazana jest czynność nanoszenia soli fizjologicznej na szkiełko.
2. Instrukcja: Nanieś pipetą kroplę soli fizjologicznej na środek szkiełka opisanego jako „Ec” (Escherichia coli). Ukazana jest czynność nanoszenia soli fizjologicznej na szkiełko.
3. Instrukcja: Za pomocą ezy przenieś jedną kolonię bakterii z szalki ze Staphylococcus aureus i delikatnie rozmaż ją w kropli. Przed każdym użyciem ezy i po jej użyciu opal ją nad płomieniem palnika w celu sterylizacji (zniszczenia drobnoustrojów). Ukazane są następujące czynności: opalanie ezy nad palnikiem, następnie przeniesienie kolonii bakterii z szalki ze Staphylococcus aureus na próbkę z napisem Sa.
4. Instrukcja Za pomocą ezy przenieś jedną kolonię bakterii z szalki z Escherichia coli i delikatnie rozmaż ją w kropli. Przed każdym użyciem ezy i po jej użyciu opal ją nad płomieniem palnika w celu sterylizacji (zniszczenia drobnoustrojów). Ukazane są następujące czynności: opalanie ezy nad palnikiem, następnie przeniesienie kolonii bakterii z szalki ze Escherichia coli na próbkę z napisem Ec.
5. Instrukcja: Suchy preparat ze Staphylococcus aureus chwyć pęsetą. Utrwal go w płomieniu palnika, przez trzykrotne przesuwanie szkiełka nad płomieniem. Odłóż preparat i czekaj, aż się ostudzi. Ukazane jest, jak osoba wykonująca doświadczenie, trzymając pęsetą preparat przesuwa nim trzykrotnie nad palącym się palnikiem.
6. Instrukcja: Suchy preparat z Escherichia coli chwyć pęsetą. Utrwal go w płomieniu palnika, przez trzykrotne przesuwanie szkiełka nad płomieniem. Odłóż preparat i czekaj, aż się ostudzi. Ukazane jest, jak osoba wykonująca doświadczenie, trzymając pęsetą preparat przesuwa nim trzykrotnie nad palącym się palnikiem.
7. Instrukcja: Preparat ze Staphylococcus aureus zalej fioletem krystalicznym, odczekaj 60 sekund. Ukazane jest jak osoba wykonująca doświadczenie zalewa preparat fioletem krystalicznym.
8. Instrukcja: Na ten sam preparat nanieś płyn Lugola, odczekaj 30 sekund. Ukazane jest jak osoba wykonująca doświadczenie zalewa po raz drugi ten sam preparat – tym razem brązowym płynem Lugola.
9. Instrukcja: Chwyć preparat za brzeg szkiełka i opłucz wodą destylowaną. Ukazane jest jak osoba wykonująca doświadczenie płucze starannie preparat. Z preparatu spływa ciemna ciecz. Na preparacie znajduje się ciemna plama.
10. Instrukcja: Opłucz preparat odbarwiaczem. Ukazane jest jak osoba wykonująca doświadczenie płucze starannie preparat. Z preparatu spływa zabarwiona na fioletowy kolor ciecz. Na preparacie znajduje się fioletowa plama.
11. Instrukcja: Preparat opłucz wodą destylowaną. Ukazane jest jak osoba wykonująca doświadczenie płucze starannie preparat. Z preparatu spływa zabarwiona na jasnofioletowy kolor ciecz. Na preparacie znajduje się jasnofioletowa plama.
12. Instrukcja: Na preparat nanieś fuksynę, odczekaj 30 sekund. Ukazane jest jak osoba wykonująca doświadczenie płucze starannie preparat fuksyną o kolorze amarantowym. Z preparatu spływa zabarwiona na amarantowy kolor ciecz. Na preparacie znajduje się jasnofioletowa plama.
13. Instrukcja: Opłucz preparat wodą destylowaną. Ukazane jest jak osoba wykonująca doświadczenie płucze starannie preparat wodą destylowaną. Z preparatu spływa zabarwiona na amarantowy kolor ciecz. Na preparacie znajduje się jasnofioletowa plama.
14. Preparat z Escherichia coli zalej fioletem krystalicznym, odczekaj 60 sekund. Ukazane jest jak osoba wykonująca doświadczenie płucze starannie preparat fioletem krystalicznym o kolorze ciemnofioletowym. Z preparatu spływa zabarwiona na ciemnofioletowy kolor ciecz. Na preparacie znajduje się ciemnofioletowa plama.
15. Instrukcja: Na ten sam preparat nanieś płyn Lugola, odczekaj 30 sekund. Ukazane jest jak osoba wykonująca doświadczenie płucze starannie preparat fioletem płynem Lugola o kolorze brązowym. Z preparatu spływa zabarwiona na brązowy kolor ciecz. Na preparacie znajduje się brązowa plama.
16. Instrukcja: Chwyć preparat za brzeg szkiełka i opłucz wodą destylowaną. Ukazane jest jak osoba wykonująca doświadczenie płucze starannie preparat wodą destylowaną. Z preparatu spływa zabarwiona na ciemny kolor ciecz. Na preparacie znajduje się ciemna plama.
17. Instrukcja: Opłucz preparat odbarwiaczem. Ukazane jest jak osoba wykonująca doświadczenie płucze starannie preparat odbarwiaczem. Z preparatu spływa zabarwiona na ciemny kolor ciecz. Preparat całkowicie odbarwia się.
18. Instrukcja: Preparat opłucz wodą destylowaną. Ukazane jest jak osoba wykonująca doświadczenie płucze starannie preparat wodą destylowaną. Z preparatu spływa zabarwiona na jasnofioletowy kolor ciecz. Preparat całkowicie oczyszcza się z barwników.
19. Instrukcja: Na preparat nanieś fuksynę, odczekaj 30 sekund. Ukazane jest jak osoba wykonująca doświadczenie płucze starannie preparat fuksyną o kolorze ciemnoamarantowym. Z preparatu spływa zabarwiona na amarantowy kolor ciecz. Na preparacie znajduje się amarantowa plama.
20. Instrukcja: Opłucz preparat wodą destylowaną. Ukazane jest jak osoba wykonująca doświadczenie płucze starannie preparat wodą destylowaną. Z preparatu spływa zabarwiona na amarantowy kolor ciecz. Na preparacie znajduje się różowa plama.
21. Instrukcja: Obejrzyj preparat ze Staphylococcus aureus pod mikroskopem. Ukazane jest zdjęcie w powiększeniu mikroskopowym. Są tu liczne, kuliste bakterie wybarwione na kolor fioletowo‑granatowy.
22. Instrukcja: Obejrzyj preparat z Escherichia coli pod mikroskopem. Ukazane jest zdjęcie w powiększeniu mikroskopowym. Są tu liczne, pałeczkowate bakterie wybarwione na kolor różowy.
23. Instrukcja: Powtórz doświadczenie.
Wynik barwienia metodą Grama
Wynik barwienia zależy od typu ściany komórkowej oraz grubości mureinymureiny. Gruba warstwa mureiny bakterii Gram‑dodatnich efektywnie zatrzymuje nierozpuszczalne w wodzie barwne kompleksy fioletu krystalicznego i jodu (zawartego w płynie Lugola). W przypadku bakterii Gram‑ujemnych barwne kompleksy są skutecznie wymywane przez alkohol z cienkiej warstwy mureiny, dlatego do ich ukazania stosuje się barwnik kontrastowy, np. fuksynę zasadową.
Z użyciem barwienia Grama większość bakterii można podzielić na dwie podstawowe grupy:
Gram‑dodatnie (G+), np. ziarniaki, laseczki, maczugowce, promieniowce – barwią się na fioletowo;
Gram‑ujemne (G−), np. pałeczki Pseudomonas, przecinkowce i śrubowce – przybierają barwę różową.
Metoda ta pozwala również uwidocznić kształt badanej komórki oraz określić jej rozmiar i inne szczegóły strukturalne. Stanowi zatem źródło wstępnych informacji taksonomicznych o badanym szczepie.
Słownik
podwójna błona fosfolipidowa, charakterystyczna cecha ściany komórkowej bakterii Gram‑ujemnych (G−); składa się z fosfolipidów, białek, lipopolisacharydu (LPS) oraz lipoprotein
barwnik trifenylometanowy; w połączeniu z fioletem metylowym tworzy mieszaninę zwaną fioletem gencjanowym
syntetyczny barwnik stosowany w barwieniu metodą Grama, służący do odróżnienia bakterii Gram‑dodatnich od Gram‑ujemnych, które barwi na różowo; wykorzystywana jest również do wyrobu farb i atramentów oraz do barwienia papieru i włókien naturalnych, a w chemii analitycznej do wykrywania bromianów oraz bromków i aldehydów; wykazuje właściwości antyseptyczne
podstawowy element szkieletu ściany komórek bakteryjnych; polimer składający się z ułożonych naprzemiennie łańcuchów N-acetyloglukozoaminy i kwasu N-acetylomuraminowego połączonych poprzecznie łańcuchami peptydowymi; biosyntezę mureiny hamują niektóre antybiotyki, np. antybiotyki beta‑laktamowe, do których należy penicylina
roztwór (1‑procentowy) jodu IIndeks dolny 22 w 2‑procentowym wodnym roztworze jodku potasu (KI); stosowany do wykrywania skrobi (w jej obecności roztwór zabarwia się na kolor ciemnoniebieski) oraz w lecznictwie jako zewnętrzny środek odkażający (do płukania gardła i pędzlowania skóry) i wewnętrznie (w chorobach tarczycy, miażdżycy naczyń)
zagrażająca życiu dysfunkcja narządowa wynikająca z zaburzonej regulacji odpowiedzi ustroju na zakażenie; odpowiedź ta powoduje uszkodzenie tkanek i narządów; zakażenia i stany zapalne wywołujące sepsę pierwotnie dotyczą różnych narządów, m.in.: jamy brzusznej, układu moczowego, układu oddechowego lub skóry